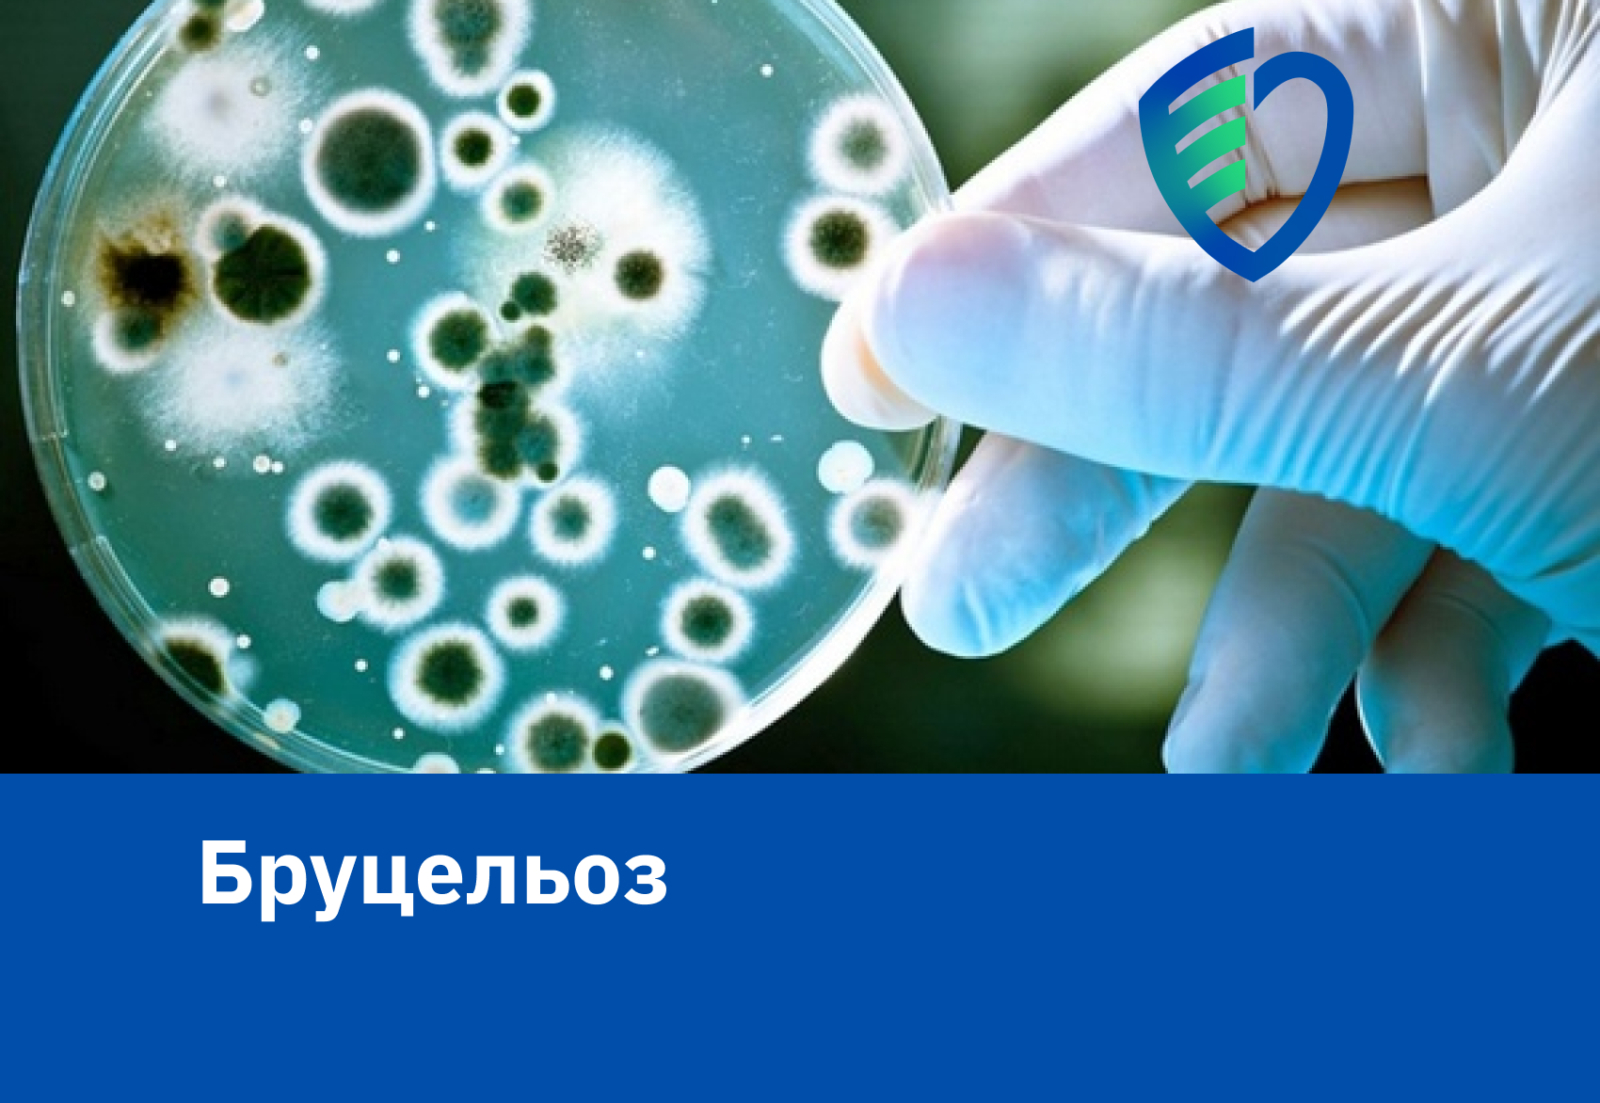

Бруцельоз
30 липня 2024
Бруцельоз – це інфекційне – алергічне захворювання, спричинене бактеріями роду Brucella, супроводжується лихоманкою, а також уражаються опорно-руховий апарат, нервова, серцево-судинна, урогенітальна та інші системи організму. На бруцельоз хворіють кози та вівці (Br. melitensis), корови (Br. abortus bovis), свині (Br. abortus suis), а також домашні тварини, собаки (Br. canis). Хвороба у тварин часто має прихований перебіг. Більш небезпечний для людини є Brucella melitensis. Від однієї людини до іншої бруцельоз не передається. Організм людини є епідеміологічний тупик, хвора людина для оточуючих небезпеки не являє. Основним джерелом інфекції для людини є велика і дрібна рогата худоба, а також свині. У тварин часто спостерігається безсимптомна форма хвороби, але найбільш характерною ознакою бруцельозу у сільськогосподарських тварин є аборт. Плід, оболонки, навколоплідна рідина містять величезну кількість збудника бруцельозу. З виділеннями збудники потрапляють назовні, заражають корм, воду в місцях водопою, а також інших тварин.
Найбільша захворюваність спостерігається серед осіб, що мають постійний контакт із хворими на бруцельоз тваринами (пастухи, чабани, ветеринари, зоотехніки, працівники м’ясокомбінатів тощо). У більшості випадків бруцельоз людей – це професійне захворювання. При недотримані техніки безпеці можливе зараження у лабораторіях , де працюють з живими культурами бруцел.

Історичні відомості
Бруцельоз відомий з часів Гіппократа, в одному з неакрополей єгипетскої Саккари, італійські археологи виявили заражений бруцельозом сир, який був виготовлений з козячого молока в період між 1290 і 1213 роками до н.е. В XVIII столітті бруцельоз часто описували під назвою мальтійської, критської, середземноморської лихоманки. В 1887 році англійський лікар Брюс відкрив збудника цих лихоманок. Надалі хворобу названо на честь Д.Брюса. В 1904 – 1907 рр. лабораторно дослідили і виявили поголовну зараженість мікрококом кіз на Мальті та інфікованість усіх продуктів, що отримували від цих тварин (молоко,бринза,сир). Заборона вживати всі ці продукти без попередньої термічної обробки призвела до різкого зниження захворюваності на бруцельоз.
Бруцели як біозброя
Проведенні дослідження показали перспективу застосування бруцел як біозброї . Стійкість їх у зовнішньому середовищі дає можливість їх перенесення у снарядах на далеку відстань. Офіційно визнані чинниками біологічної зброї збудники бруцельозу: Brucella abortus suis, melitensis. Також дослідження показали слабку здатність бруцел спричинювати смертність, летальність наставала через місяці після ураження.
Шляхи передавання інфекції
Людина найчастіше заражається бруцельозом аліментарним шляхом, при вживанні заражених молочних продуктів (молока, сирів та ін..) та м’яса, які не пройшли термічної обробки. Рідше – контактним та аерогенним шляхом, збудник який виділяється від хворої тварини з фекаліями, сечею, з навколоплідними водами, через слизові оболонки та мікротравми на шкірі потрапляє до організму людини. Також під час стриження хворих овець або при прибиранні приміщень, при вдиханні частинок пилу (аерогенний шлях). Переносниками Brucell є жигалки осінні та кліщі, при їх укусах збудник також потрапляє до організму людини.
Бруцельоз поширений в багатьох країнах світу, сприйнятливість до бруцельозу висока. Так, країни Середземномор’я – Греція, Іспанія, Італія – є високо ендемічними, реєструється висока захворюваність на бруцельоз не лише тварин, а й людей. Туристи які відвідують ці країни та не дотримуються правил профілактики, часто заражаються на бруцельоз. При несвоєчасному лікуванні , у 30-80 % випадків хвороба переходить в хронічну форму та може закінчитися інвалідністю.
Симптоми бруцельозу
Скарги хворого на бруцельоз:
- головний біль;
- хвилеподібна лихоманка ;
- мігруючі білі у суглобах та м’язах ;
- стомлюваність, слабкість ;
- відсутність апетиту;
- підвищення потовиділення (піт схожий на плісняву);
- блювання, діарея, біль у животі;
- не виношування вагітності.
Інкубаційний період при бруцельозі триває від 3 днів до декількох тижнів. При потраплянні Brucell до організму людини, клітини імунної системи частково поглинають їх і потім з потоком лімфи потрапляють в лімфоїдні вузли, де вони можуть локально розмножуватися. Також розмноження може відбуватися в печінці, селезінці, нирках, в тканинах молочної залози або суглобах, викликаючи як локальну так і системну інфекцію. Найбільш важкий перебіг бруцельозу у людини викликає мелітенсіс (яким хворіють кози та вівці). Якщо своєчасно не розпочати лікування, бруцельоз схильний до хронічної течії. Після перенесеної хвороби у людини формується імунітет, але не тривалий, через 3-5 років можливе повторне зараження. Найчастіше хвороба виникає в весняно – літній період.
Найчастіше бруцельоз починається гостро, температура тіла підвищується до 39-40 °С, виникає озноб, потовиділення, слабкість, біль у м’язах та суглобах, рух в суглобах обмежується. Але хвороба може розвиватися поступово, при цьому характерні: субфебрильна температура тіла (до 38°С), головний біль, безсоння, зниження апетиту, дратівливість, виникає біль в суглобах та м’язах, лімфатичні вузли збільшуються. Через деякий час підвищується температура тіла і всі симптоми посилюються. Ці прояви то стихають , то знову посилюються упродовж 3-4 тижнів. При встановленні діагнозу дуже важливо ретельно зібрати анамнез і якщо ви мали контакт з тваринами протягом останніх двох місяців, важливо про це повідомити лікарю.
Як уберегти себе та близьких від бруцельозу?
- вживайте лише термічно оброблені молочні та м’ясні продукти ;
- не купуйте молочні та м’ясні продукти на стихійних ринках;
- не вживайте сире молоко, сири, бринзу , особливо від кіз;
- своєчасно вакцинуйте тварин;
- робітники із групи ризику також повинні вакцинуватися (ветеринари,зоотехніки, пастухи та ін..);
- контроль за у боєм худоби;
- хворі та інфіковані на бруцельоз тварини підлягають знищенню або ізоляції;
- при роботі з хворими тваринами застосовують захисний одяг (гумові рукавички, гумові чоботи, респіратор, захисні окуляри та ін..) і дезінфекційні речовини (розчин хлораміну, лізолу). До роботи з інфікованими тваринами допускаються особи, вакциновані проти бруцельозу.
- в ендемічних на бруцельоз районах люди підлягають обов’язкової вакцинації. Щеплення роблять живою бруцельозною вакциною.
Лікування
Передбачається комплексне лікування з застосуванням антибіотиків, протизапальних та симптоматичних препаратів. Brucella розташовується внутрішньоклітинно і потребує тривалого , безперервного введення антибактеріальних препаратів . У разі тяжкого перебігу процесу зі значною інтоксикацією призначають глюкокортикоїди.
Стійкість
Brucella у зовнішньому середовищі має досить високу стійкість. Дуже добре зберігається у висушених субстратах, виділених від хворих тварин. В молоці зберігається на протязі 1-3 днів, в бринзі, м’ягких сирах – 1-3 міс , інколи до 12 міс. При кип‘ятінні молока та термічній обробці м‘яса бактерії гинуть дуже швидко. Продукти, приготовлені з сирого молока, перед вживанням витримують протягом певного терміну ( не менш 3 міс). У воді Brucella зберігає життєдіяльність біля 2 місяців.
У світі щорік реєструється понад 500 тис. випадків захворювань на бруцельоз. 60% випадків реєструється серед населення віком від 13 – 40 років, 16% – у осіб віком 40 – 60 років та 2,5% – у осіб віком 60 років та старших. В Україні в 2024р. зареєстровано один випадок бруцельозу (в Чернівецькій обл.), в Херсонській області – випадків не зареєстровано.
Бережіть себе, дбайте про здоров’я рідних та близьких !



